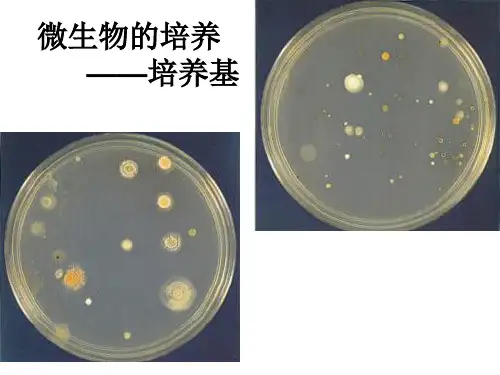

高压蒸汽 灭菌法
紫外线 消毒 化学药物 消毒
主要方法
高 压 蒸 汽 灭 菌 锅 内 ,100 kPa,121 ℃ 下 持 续 加 热 15~30 min
30 W 紫外线灯照射 30 min
用体积分数为 70%~75%的 乙醇、碘酒涂抹等
应用范围
续表
培养基等
接种室空气等
用于皮肤、伤口、动植物组织表面 消毒,手术器械、玻璃器皿等消毒
专题 2 微生物的培养与应用
目录 退出
课题 1 微生物的实验室培养
目录 退出
课前预习导学
目标导航
学习目标
1.了解有关培养基的基础知识。 2.进行无菌技术的操作。 3.进行微生物的培养。
重点难点 重点:
1.进行无菌技术的操作。 2.进行微生物的培养。 难点:正确进行无菌技术的操作。
目录 退出
预习导引
目录 退出
3.学习教材第 18 页平板划线操作,思考下列问题。 (1)为什么在操作的第一步以及每次划线之前都要灼烧接种环?在 划线操作结束时,仍然需要灼烧接种环吗? 提示:操作的第一步灼烧接种环是为了避免接种环上可能存在的 微生物污染培养物;以后每次划线前灼烧接种环是为了杀死上次划线 结束后,接种环上残留的菌种,使下一次划线时,接种环上的菌种直接来 源于上次划线的末端,从而通过划线次数的增加,使每次划线时菌种的 数目逐渐减少,以便得到单菌落。划线结束后需要灼烧接种环,能及时杀 死接种环上残留的菌种,避免菌种污染环境和感染操作者。
目录 退出
3.培养基灭菌后,需要冷却至 50 ℃左右时,才能用来倒平板。你用 什么办法来估计培养基的温度?
提示:可以用手触摸盛有培养基的锥形瓶,感觉锥形瓶的温度下降 到刚刚不烫手时,就可以进行倒平板了。